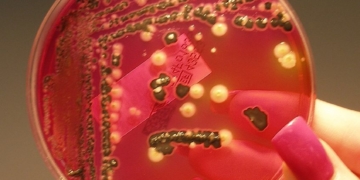
Canada’s Public Health Agency says Salmonella Outbreak Hits 6 Provinces, Dozens sick and Two Dead
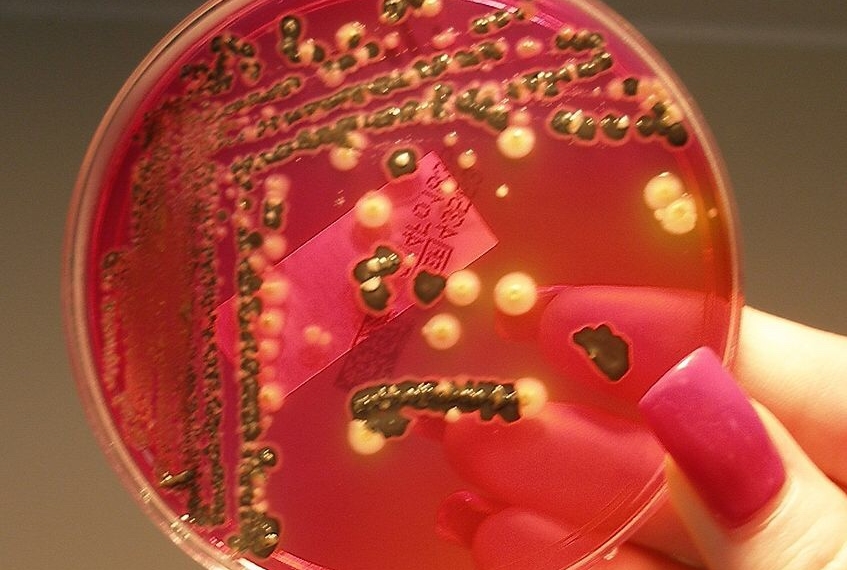
Canada’s Public Health Agency says Salmonella Outbreak Hits 6 Provinces, Dozens sick and Two Dead

Ottawa, ON (WNews)- Health officials in Canada are investigating an outbreak of salmonella in six provinces that has sickened 63 people, including 18 who have been hospitalized.

The Public Health Agency of Canada says there are laboratory-confirmed cases in British Columbia, Alberta, Saskatchewan, Manitoba, Ontario and Quebec.
The health agency says the source of the bacterial infection has not been identified.
“The Canadian Food Inspection Agency is conducting a food safety investigation,” a government release says. “If contaminated food products are identified, they will take the necessary steps to protect the public, including recalling food products as required.
“Currently there are no food recall warnings associated with this outbreak.”
There’s has been two deaths reported but has not been confirmed or linked. Two reported in Winnipeg at a personal care home after testing positive for salmonella.
The agency says the people who became ill range in age from one to 87. Individuals became sick between November and March.
The agency said anyone can become sick from salmonella but infants, children, seniors and those with weakened immune systems are at higher risk of serious illness.
Salmonella is a common bacteria that causes intestinal illness. Symptoms may include chills, diarrhea, abdominal cramps, fever, nausea, and vomiting.
It is usually caused by eating contaminated foods that have not been cooked properly but can also be spread from one person to another if people don’t wash their hands after using the bathroom.
the breakdown of known cases as of Friday includes 23 people in B.C., ten people each in Alberta, Manitoba and Ontario. There are eight cases in Saskatchewan and two in Quebec.
The Canadian Food Inspection Agency has recalled frozen chicken nuggets three times this year over fears of salmonella contamination.